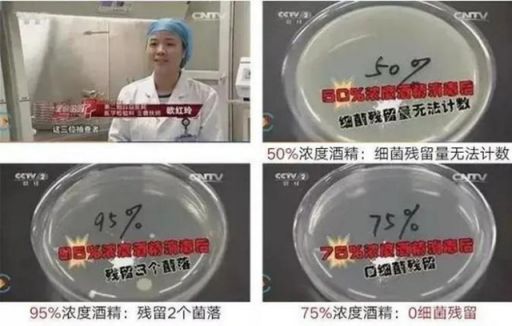

含75%酒精和75%酒精一样吗?75%酒精湿巾怎么辨别真假
李兰娟院士说75%左右浓度的酒精可以杀死新型冠状病毒,酒精产品比如:酒精湿巾、酒精喷雾、酒精洗手液等市场爆发,产品也是琳琅满目,让人应接不暇。酒精产品可以说是除了口罩之外最抢手的东西了。其中,由于酒精湿巾携带方便、安全(酒精喷雾有安全隐患),不仅能擦手,也能擦拭物体硬表面,格外走俏。正是因为人们对酒精湿巾的需求量上涨,所以假货也开始到处都是。
那么怎么辨别75%酒精的真假呢?下面就由小编来给大家说说吧!
首先,某些厂家使用的酒精是假酒精,假的酒精不是乙醇而是95%的甲醇。甲醇不但没有消毒的作用,而且还有一定的毒性。 如果不小心买到了假酒精,就会经呼吸道和皮肤摄入体内产生毒性。短时大量吸入可能出现轻度眼、上呼吸道刺激症状,经一段时间潜伏期后可能出现头痛、头晕、乏力、眩晕、酒醉感、意识朦胧、谵妄,甚至昏迷。视神经及视网膜病变,可有视物模糊、复视等,重者失明等。 划重点!辨别真假的方法就是闻气味,假酒精一点酒精的气味都没有,但是可以点燃。
其次,酒精分为:医用酒精、工业酒精、食用酒精。医用酒精必须符合《中国药典》可用于制药行业。以酒精湿巾为例,购买时要认准医用酒精,不要踩坑了!
最后,小编给大家科普下。酒精之所以能消毒是因为酒精能够吸收细菌蛋白的水分,使其脱水变性凝固,从而达到灭菌的目的。经实验表明,酒精浓度过高,会在细菌表面形成一层保护膜,无法进入细菌体内,难以将细菌彻底杀死;浓度过低,虽然可以进入细菌,但却不能将蛋白质凝固,同样也不能将细菌彻底杀死。75%左右浓度的酒精可以在细菌表面蛋白未变性前逐渐不断地向细菌内部深入,使细菌蛋白脱水、变性凝固,最终达到灭菌效果。所以选产品时一定要选真75%酒精产品,酒精配比足。
某些产品写的是”含75%酒精“,看到”含“这个字就要当心了,这里就有猫腻啦!出于成本考虑,某些厂家选用的并非真正75%酒精,而是稀释了的酒精,浓度远远达不到75%。专人人士指出,酒精含量不足75%的酒精湿巾,其实只是用酒精消过毒的湿巾,别被不良商家坑啦!只有酒精含量达到75%,才是真正75%酒精湿巾。

还有,合格的酒精湿巾是一定要有卫生许可证的,购买时一定要认准消字号!
关于如何辨别75%酒精真假,我自己也研究了几个办法,在这里分享给各位:
第一个办法是闻一闻,酒精含量高的湿巾,味道特别重,冲鼻子,我第一次闻的时候,猝不及防,不知道多大味儿,结果猛吸了一口气,头晕了半个小时,简直是用“绳命”在测试啊。你们闻的时候,一定小口吸气。
第二个办法拧一拧,取出湿巾之后,用力拧,如果拧不出东西来,证明酒精含量太少,不够湿润,擦不干净;如果水分含量太高,会往下滴;如果是75%酒精,只会顺着手流。
第三个办法是晾一晾,把75%酒精湿巾放在窗台上晾晒,然后几分钟摸一下,闻一下,到7分钟的时候,酒精味道依旧浓厚,到9分钟的时候,酒精味道不太大了,到11分30秒的时候,湿巾只是微微湿一点,到13分钟的时候,摸起来就跟摸干棉花差不多了。
第四个方法是烧一烧,75%酒精湿巾轻易就会烧着了,火苗非常大,如果酒精含量少,火苗不会这么大。但是,无纺布却没有点着,酒精烧完之后,可以直接用手去摸,无纺布就跟棉花一样又干又柔。然后,再点燃无纺布,很轻松就点着了,证明大部分水都挥发掉了。
这证明,酒精挥发完之后,水分有很快挥发完了,水的含量,并不高;如果酒精味道没了,但是湿巾一直很湿,那就“太水了”!
经过这四步证明,基本上就可以判断一款75%酒精湿巾到底是好是坏。

小编从朋友那拿了一包Dr.Parmar帊玛医生75%酒精湿巾,据说是李佳琪直播间抢来的。先看,Dr.Parmar帊玛医生75%酒精湿巾具备上海消字号,外资企业生产,靠谱!品质放心!再看外包装,上面写的也是真正75%酒精,完全符合上述标准。小编心里已经对这款产品越来越有好感了!拆开包装,闻一闻味道,让人”上头的“酒精味道扑面而来,让人倍感安心。取出一张拧一拧,液体顺着手流下来。最后,小编还取了一张湿巾进行燃烧测试,也顺利通过测试。
小编网上搜索了下,Dr.Parmar帊玛医生75%酒精湿巾坚持使用符合《中国药典》规范的药品级医用酒精原料,配比足量(湿巾整体挤出液中酒精体积占比达到75%),杀菌率高达99.9%。

配料采用的是更高品质的EDI去离子纯水,比RO水更纯更放心。Dr.Parmar帊玛医生采用医药级EDI纯水设备、产出符合FDA美国药典标准的医药级用水,可用于药品生产;EDI去离子纯水经过12层净化处理,达到无污、无盐、无杂质,至纯至净,长期使用更放心;另外还添加了甘油护肤,防止皮肤干燥。

Dr.Parmar帊玛医生75%酒精湿巾使用的是浮点水刺无纺布,细腻厚实、不起絮、抗拉扯,而且无荧光剂、染色剂和香精,不产生二次污染,对皮肤无刺激!
此外,Dr.Parmar帊玛医生选择为知名品牌和世界500强公司生产的专业湿巾制造商AHC美馨强强联手,品质放心。
AHC美馨是一家专业湿巾制造商,也是国内较早从事湿巾制造的外商独资企业。企业已通过ISO9001、ISO13485、BRC-CP、EPA、FDA、GMPC、BRC-CP、BSCI等国际认证。
此文内容为企业宣传资讯,仅代表作者个人观点,与本网无关。仅供读者参考,并请自行核实相关内容。如果您发现网站上有侵犯您的知识产权的作品,请与我们取得联系,邮箱: zixunrexian@126.com ,我们会及时修改或删除。
网址:含75%酒精和75%酒精一样吗?75%酒精湿巾怎么辨别真假 https://c.jiaju82.com/news-view-id-706610.html

